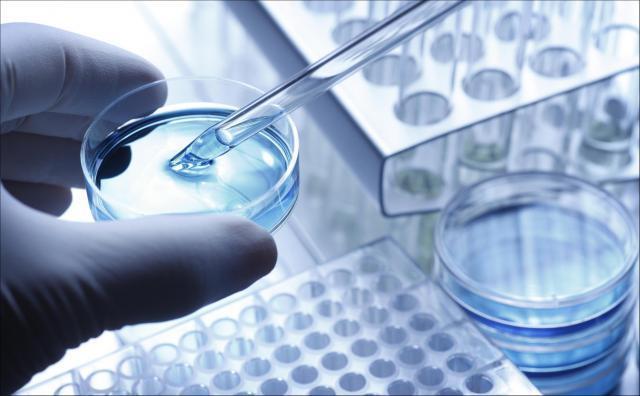
天使轮达30亿美元，生命科学领域最大一笔融资引爆这一赛道

手机壳超好卖,刚需干不过的配饰
科技热搜 华为mate 淘宝 华为 iphone 融资 新闻 资讯 直播 视频 美图 社区 本地 热点 2023-09-26
天使轮达30亿美元,生命科学领域最大一笔融资引爆这一赛道
科技热搜 融资 抗衰老 生物 创始人 编程 新闻 资讯 直播 视频 美图 社区 本地 热点 2023-09-25

万亿预制菜,暂缓进校园
科技热搜 格力 工业化 融资 饮食男女 杭州 新闻 资讯 直播 视频 美图 社区 本地 热点 2023-09-24

广汽埃安:隐忧不少,何以“封神”?
科技热搜 广汽埃安 广汽集团 网约车 新能源汽车 融资 新闻 资讯 直播 视频 美图 社区 本地 热点 2023-09-23

融资150亿,最凶猛独角兽诞生:破国家纪录
科技热搜 融资 电动车 雷诺 锂电池 欧盟 新闻 资讯 直播 视频 美图 社区 本地 热点 2023-09-21

不上市,就完蛋?新能源车第二波IPO浪潮到来
科技热搜 融资 新能源 ipo 新能源车 蔚来 新闻 资讯 直播 视频 美图 社区 本地 热点 2023-09-19

理想汽车CEO李想:融资上造假的“造车新势力”都死光了
科技热搜 威马汽车 融资 apollo 造假 it之家 新闻 资讯 直播 视频 美图 社区 本地 热点 2023-09-19

花光数百亿,威马汽车“卖身”求生机
科技热搜 威马 开心汽车 融资 威马汽车 小鹏 新闻 资讯 直播 视频 美图 社区 本地 热点 2023-09-18

2023年最大的“流血上市”,估值直降2100亿
科技热搜 ipo 独角兽 融资 招股书 老虎基金 新闻 资讯 直播 视频 美图 社区 本地 热点 2023-09-17

李想:创始人吃里扒外融资金额造假的车企都死光了
科技热搜 李想 造假 融资 小鹏 ceo 新闻 资讯 直播 视频 美图 社区 本地 热点 2023-09-17